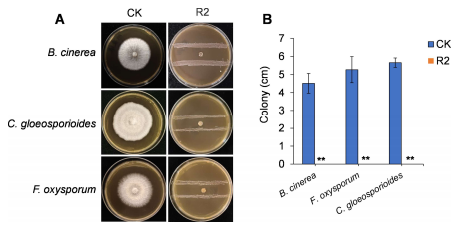

本站讯(通讯员 王永梅)近日,海南大学南繁学院 2022 级种子科学与工程专业学生张曦予在安邦教授的悉心指导下以第一作者在中科院二区期刊《Journal of Fungi》发表题为“Biocontrol Potential of a Mango-Derived Weissella paramesenteroides and Its Application in Managing Strawberry Postharvest Disease”的研究论文,该项研究成果为果蔬采后病害绿色防控提供了新方案。
图1 菌株R2对采后真菌病原菌的体外拮抗活性
真菌性病害是造成果蔬采后腐烂和经济损失的主要原因,针对这一产业痛点,研究团队从芒果表皮分离获得一株植物源魏斯氏菌(Weissella paramesenteroides R2)。经研究发现,R2菌株对常见植物病原真菌具有强抑菌作用,其产生的挥发性有机化合物(VOCs)能有效抑制真菌菌丝生长。通过GC-MS技术鉴定出了84种挥发性有机化合物(VOCs),并确认其中3种具有强抑菌效果,在草莓保鲜实验中表现优异。
南繁学院始终注重本科生科研能力培养,通过导师制、科研训练项目等方式,为学生提供高水平科研平台。该研究成果充分展现了学院在“新农科”建设和创新型人才培养方面的突出成效。未来,学院将继续深化教育教学改革,为海南自贸港建设和国家种业振兴培育更多高素质创新人才。
简介:张曦予,海南大学南繁学院2022级种子科学与工程专业本科生,大二期间进入重要热带作物抗病分子机理与分子育种团队,主要研究乳杆菌和真菌。目前已作为第一作者在《Journal of Fungi》上发表学术论文1篇。

编辑:陈艳丽
审核:黄东益